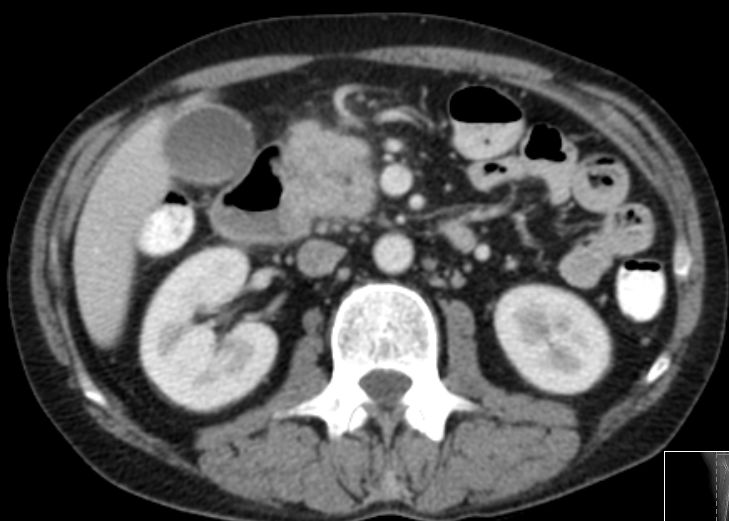

Pankreas - Karzinom: Metastasen
Verschlussikterus, Bilirubin 99.








Teil von

Pankreas - Karzinom: Metastasen | ||||
| Allgemeines | ||||
| Lokalrezidiv | 48-jähriger Mann mit Pankreaskopfkarzinom. Verschlussikterus, Bilirubin 99.  |
CT: Einbruch ins Duodenum
|
||
| Lokalrezidiv | 77-jährige Frau 9 Monate nach pyloruserhaltender Pankreaskopfresektion. Das Rezidiv hat die Vena portae eingegengt. |
|||
| Knochen - Metastasierung |  |
 |

| |
| Leber - Metastasierung |  |
48-jähriger Mann mit hepatisch metastasiertem Pankreaskopf-Karzinom.
Histologische Sicherung vor 6 Monaten: schlecht differenziertes Adenokarzinom. Chemotherapie: FOLFOXIRI. Restaging: Progress. Leber mit Metastasen durchsetzt. |
||
Teil von |
Pankreas - Karzinom | Gastro - Intestinale Tumore | ||
 | ||||
Impressum Zuletzt geändert am 16.09.2012 21:12